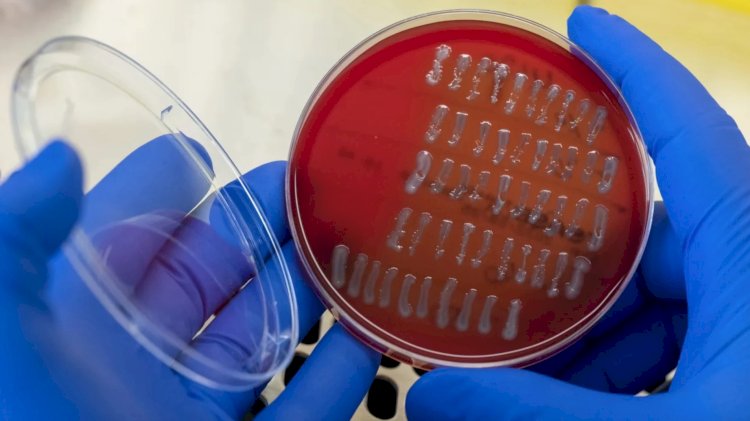
مراكز مكافحة الأمراض تُحذّر من الأطعمة الملوثة

مساحة إعلانية

أوضحت المراكز الأمريكية لمكافحة الأمراض والسيطرة عليها (CDC) أنّ خطر الإصابة بالمرض من بكتيريا "إي كولاي" والسالمونيلا والليستيريا وغيرها من الجراثيم المنقولة بالغذاء قد ارتفع إلى مستويات ما قبل الجائحة، عام 2022.
وتناولت الوكالة في تقريرها معدلات الإصابة بالأمراض والوفيات كالتالي: لم يُلاحَظ أي تقدم لجهة الحد من إصابات العدوى (المعوية) خلال عام 2022، مع استقرار تأثيرات جائحة كوفيد-19
وتابعت الوكالة: هناك حاجة إلى التعاون بين مزارعي الأغذية ومحلات البيع بالتجزئة والمطاعم والمنظمين، للحد من التلوث الذي يتسبب بالمرض أثناء ذبح الدواجن ومنع تلوث الخضار الورقية
وتعد الـ"إي كولاي" بكتيريا شائعة لكن بعض السلالات قد تكون خطيرة، حيث تسبّب الإسهال وأمراض الجهاز التنفسي والالتهاب الرئوي وحتى الموت وفقًا لمراكز مكافحة الأمراض.
وسنويًا يمرض حوالي 9 ملايين أمريكي جرّاء مسبّبات الأمراض في الغذاء وفقًا لشبكة المراقبة النشطة للأمراض المنقولة بالغذاء التابعة لمراكز مكافحة الأمراض والسيطرة عليها
وتُعرف أيضًا باسم FoodNet وهي تراقب العدوى المشخّصة التي تسببها ثمانية من مسببات الأمراض الشائعة المنقولة من طريق الأغذية في 10 مواقع بالولايات المتحدة ويتم إدخال حوالي 56 ألف شخص إلى المستشفيات، ويموت 1,350 شخصًا سنويًا وانخفض عدد هذه الأمراض خلال فترة الجائحة بسبب "التعديلات السلوكية وتدخلات الصحة العامة والتغيرات في ممارسات البحث عن الرعاية الصحية والاختبار لكنّ البيانات الأولية لعام 2022 كشفت عن ارتفاع هذه الأرقام مجددًا
وسُجّلت أيضًا زيادة في الأمراض المرتبطة ببكتيريا موجودة في لحم الخنزير غير المطبوخ جيدًا تسمى yersinia وبكتيريا تُسمى vibrio وهي مرتبطة بتناول المأكولات البحرية غير المطبوخة جيدًا وبكتيريا تسمى cyclospora التى غالبًا ما ترتبط بالمنتجات الطازجة المستوردة.
يقول الخبراء إنّ غسل اليدين وتجفيفهما جيدًا هو العامل الأكثر أهمية لمنع انتشار التهابات الجهاز الهضمى وتشمل النصائح الرئيسية الأخرى عدم ترك طعامك خارجًا في درجة حرارة الغرفة لساعات طويلة وكن حذرًا جدًا من طريقة تعاملك مع اللحوم النيئة، ضمنًا الدواجن واغسل يديك عند التعامل مع اللحوم، وتجنب تلويث الأسطح، وقم بطهي أي لحم جيدًا. وتعتبر اللحوم المفرومة، مثل الهاجبرغر مرشحة بشكل خاص للبكتيريا الكامنة.
ويكمن الخطر في طحن اللحوم معًا وزيادة احتمال اختلاط البكتيريا السطحية بداخل اللحم، على عكس قطع شرائح اللحم ولا تنس غسل الخضار الورقية جيدًا، فهي تشكل مصدرًا رئيسيًا آخر للعديد من الجراثيم وكذلك الفاكهة والخضار الأخرى إذا لم تفعل ذلك فيمكنك حمل البكتيريا السطحية إلى قلب الخضار أو الفاكهة أثناء تقطيعها